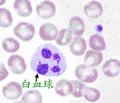
健康檢查系列~血液常規檢查Blood Routine;CBC

產品-宏泰醫事檢驗所
加入時間:2010-04-05
宏泰
公司位置:嘉義市-東區
統一編號:10812914
聯絡人:邱醫檢師
電話:05-2277909
手機:0952008588
服務時間:08:00AM - 18:00PM、每週日&每年農曆除夕至初四公休
聯繫詢價
產品介紹
目前刊登:10筆
-
健康檢查系列-完整的血脂肪檢查
血中脂質的含量和食物的攝取及身體的新陳代謝狀態有關。 通常食用高熱量及油脂類食物會令血脂肪升高。而血脂肪過高是造成心臟血 -
健康檢查系列~心臟功能檢查
心臟功能的初步檢查大概包含兩個部份: 一、心電圖檢查: 1、隨機靜態心電圖檢查:僅擷取2~5秒鐘心跳,心率不整的檢出率偏 -
健康檢查系列~血液常規檢查Blood Routine;CBC
血液常規檢查Blood Routine或簡稱CBC -

日本核電廠爆炸的輻射塵飄到台灣!!!!怕嗎?如何防護???
現代的生活環境中,充斥著各種環境汙染物、病毒、電磁波、放射線、紫外線…等,如今又有日本的輻射塵飄到台灣,這
-
賣家- 搶商機
-
導電膠 以下協助
來自:國OO山OO 詢價
***ooao@gmail.com
-
可以更換離心機內部的轉筒嗎
來自:美OO技OO有OO司 詢價
***en.chen@mmsoap.com.tw
-
過敏原檢測費用詢問
來自:蔡OO 詢價
***83917151@gmail.com
https://1391742470390.web66.tw台北三軍總醫院
簡稱三總醫院或三總,成立於1946年,為國防醫學院之教學醫院,三總與榮總、台大醫

https://minsheng.web66.com.tw/web/NMD?postId=1018771我懷疑我男友背叛我,我想安排全身性病檢查